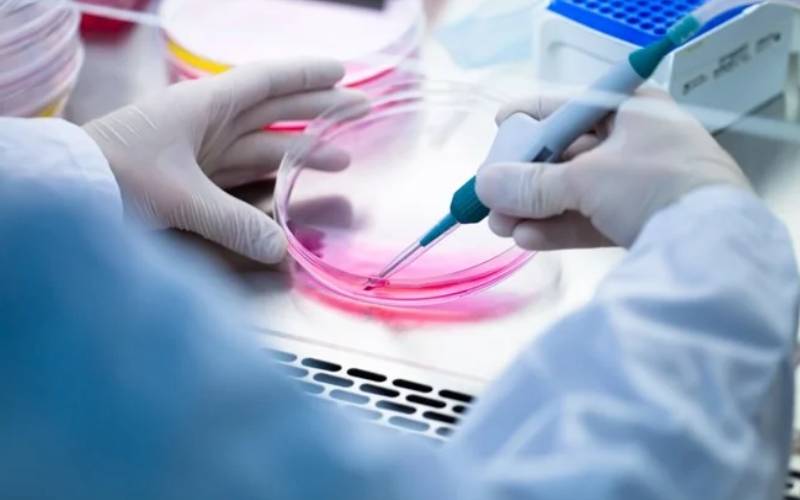

Mycoplasma in Cell Culture: Detection, Prevention, and Impact on Research Data
Cell culture is the backbone of modern biomedical research, but its reliability depends on maintaining contamination-free conditions. Among the most common and insidious contaminants is mycoplasma—a wall-less bacterium that often goes undetected, quietly altering cellular physiology, gene expression, and experimental outcomes. Studies suggest that 15–35% of continuous cell cultures worldwide are contaminated with mycoplasma at any given time (Uphoff & Drexler, 2014).
For researchers, the presence of mycoplasma not only compromises data integrity but can also lead to wasted time, funding, and reputational damage. In this article, we’ll explore how mycoplasma contamination affects cell culture, methods for detection, best practices for prevention, and why sourcing authenticated, mycoplasma-free cell lines is essential.
What is Mycoplasma and Why Is It a Problem?
Mycoplasmas are the smallest self-replicating prokaryotes, lacking a cell wall. Their unique biology allows them to:
- Pass through standard 0.2 μm filters used in sterilization.
- Resist many common antibiotics (such as penicillin, which targets cell walls).
- Persist in cultures without visible signs of contamination.
Unlike bacterial or fungal contamination, which is obvious due to turbidity or pH change, mycoplasma infections remain hidden. Yet, they can:
- Alter cell morphology and growth rates.
- Disrupt DNA, RNA, and protein synthesis.
- Interfere with metabolic activity and signaling pathways.
- Skew drug sensitivity assays.
The result? Data that appears valid but is fundamentally unreliable.
Sources of Mycoplasma Contamination
Common sources include:
- Cross-contamination from infected cell cultures.
- Lab personnel, via aerosols or saliva.
- Reagents such as contaminated serum or media.
- Improper aseptic technique during handling.
Because mycoplasma spreads easily in shared incubators and hoods, a single contaminated flask can put entire projects at risk.
Methods for Detecting Mycoplasma
- DNA Staining (e.g., Hoechst 33258, DAPI)
Fluorescent stains bind to DNA and can reveal extranuclear DNA in mycoplasma. Fast and inexpensive, but low sensitivity and requires fluorescence microscopy.
- Culture Methods
Inoculating samples on specialized mycoplasma agar/broth. Considered a gold standard, but slow (2–4 weeks).
- PCR-Based Detection
Polymerase chain reaction (PCR) identifies mycoplasma-specific DNA sequences. Sensitive, rapid (a few hours), and widely used.
- ELISA or Biochemical Assays
Detect metabolic by-products of mycoplasma. Useful for routine screening but may have false negatives.
- Commercial Mycoplasma Detection Kits
Validated kits (PCR or luminescence-based) are widely available, offering user-friendly protocols for regular testing.
Best practice: Screen all cultures every 4–8 weeks, and always test new cell lines before use.
Prevention Strategies
- Source Authenticated, Mycoplasma-Free Cell Lines
Start clean: purchase only from reputable suppliers who provide Certificates of Analysis (CoA) including mycoplasma-free verification.
- Maintain Strict Aseptic Technique
- Use designated pipettes and media for each line.
- Avoid sharing bottles or flasks between lines.
- Regularly disinfect incubators and hoods.
- Quarantine New Cell Lines
Test and culture separately before introducing into the main lab.
- Limit Antibiotic Use
While tempting, routine antibiotic use masks poor technique and may select resistant mycoplasma strains. Use only for short-term rescue.
- Establish a Monitoring Program
Incorporate mycoplasma screening into lab SOPs. Document results for reproducibility and compliance with journal/publication standards.
Impact on Research Data
Mycoplasma contamination has profound consequences:
- Gene expression studies: Expression profiles can be significantly altered, leading to false associations.
- Protein assays: Mycoplasma enzymes degrade proteins, confounding Western blots or ELISA results.
- Drug development: Contaminated cells may show false drug resistance or sensitivity.
- Reproducibility crisis: Contaminated lines contribute to irreproducible results, a major issue in biomedical research.
Many top-tier journals and funding bodies (e.g., NIH, Nature, ATCC guidelines) now require proof of mycoplasma testing before publication or grant reporting.
Case Example
A lab performing high-throughput screening of kinase inhibitors found unexpected resistance in multiple cancer lines. Routine PCR testing later revealed widespread mycoplasma contamination. After switching to authenticated, mycoplasma-free lines, assay results normalized—highlighting how contamination can derail months of costly work.
Why Supplier Choice Matters
Reliable research begins with clean starting material. At Celltech Discovery, we provide:
- Mycoplasma-free, STR-profiled human cell lines.
- Certificates of Analysis with every order.
- Validated shipping conditions (dry ice or LN₂ dry shippers) to preserve viability.
- Technical support for thawing, culturing, and contamination prevention.
By sourcing authenticated, contamination-free lines, you protect your data quality and ensure compliance with publishing standards.
Conclusion
Mycoplasma contamination is a hidden but serious threat to research integrity. Detecting it requires regular testing, preventing it requires strict aseptic technique, and avoiding it altogether begins with sourcing trusted, mycoplasma-free cell lines.
Choosing a high-quality supplier not only saves time and funding but also strengthens the credibility of your publications and grant applications.
Looking for authenticated, mycoplasma-free human cell lines? Browse our catalog at Celltech Discovery and request a quote today.
